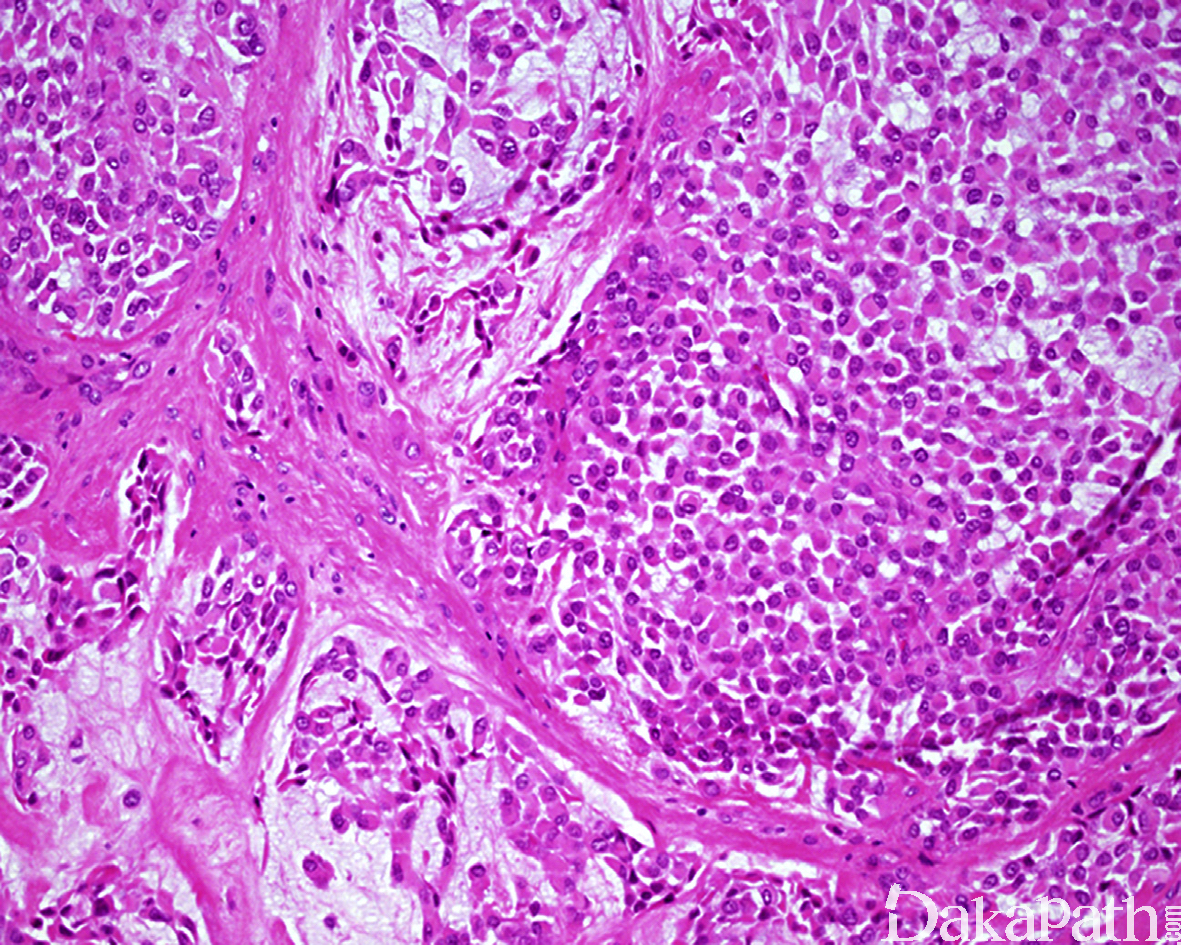
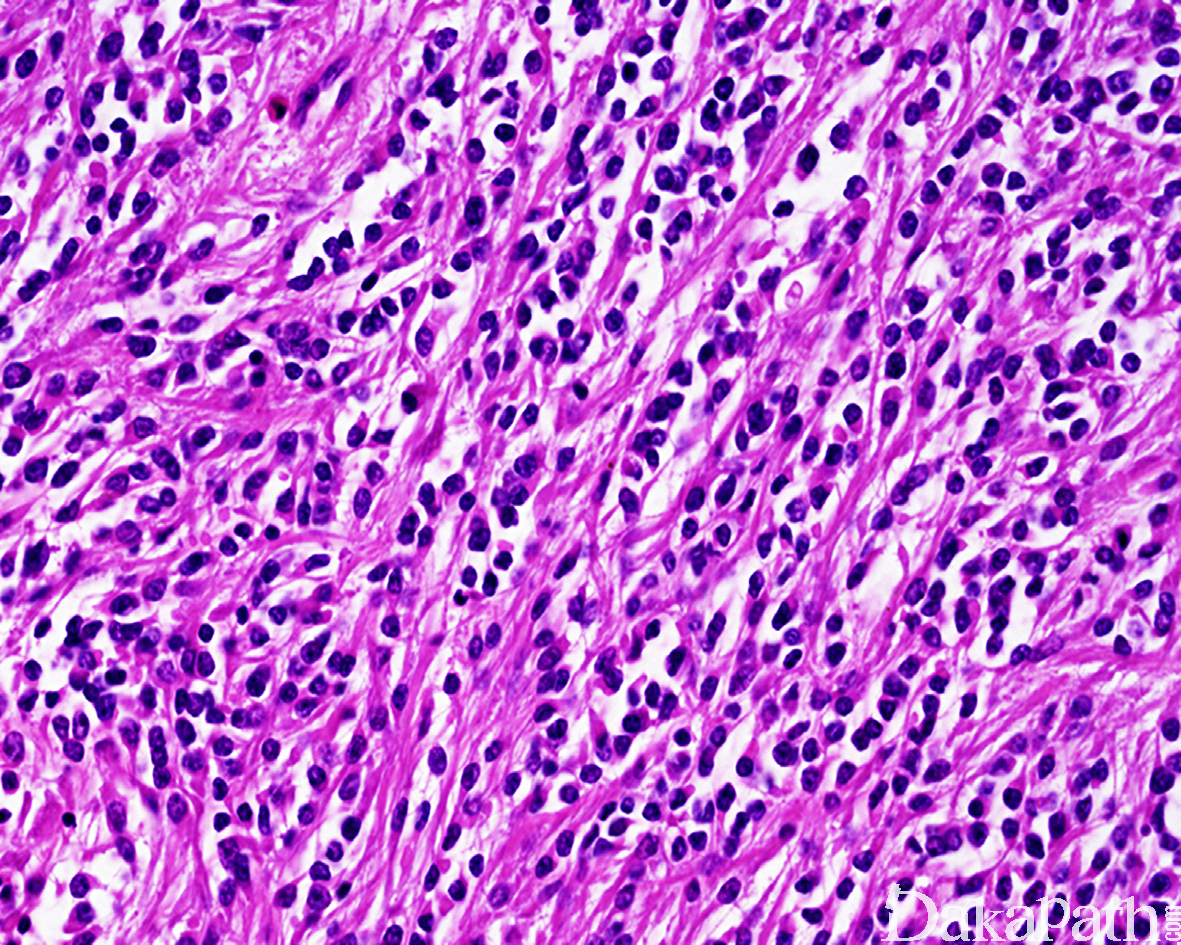

软组织肌上皮瘤
Soft tissue myoepithelioma
同义词(或曾用名): 软组织混合瘤,软骨样汗管瘤,软组织副脊索瘤
概述:
发生于软组织的组织学类似于皮肤或涎腺的肌上皮肿瘤;混合瘤指的是具有肌上皮分化的肿瘤内含有可识别的上皮性小管,软骨样汗管瘤是同义词,副脊索瘤是组织学亚型;肌上皮肿瘤显示明显的核异型性和活跃的核分裂称之为肌上皮癌,但目前尚无明确的标准用于区分良性和恶性的肌上皮肿瘤。
发病部位: 肌上皮瘤多见于肢体和躯干,肢端部位如手和足亦可发生;混合性较常见于头颈部。
诊断要点:
1,任何年纪均可发生,但多见于 30-50 岁成年人,肌上皮癌可发生于婴儿和青少年;大多数肌上皮瘤可能是皮肤附属器起源,因此常位于皮肤,也可发生于深部软组织和骨内;
2,瘤体大小不等,可从不到 1cm 至 10cm 以上,多数不超过 4cm, 而较大的肿瘤常常位于深部软组织;
3,大体上肿瘤相对界限清楚,部分可有包膜,灰白色可伴有软骨样或黏稠感;
4, 镜下组织学变化较大,低倍镜下略呈分叶状或多结节状生长。组织学上可表现为纯的梭形细胞形态,亦可表现为实性成片的上皮样细胞伴有小管形成,或表现为巢状、梁状、索状或簇状或网状的上皮样细胞位于纤维硬化性或黏液性基质内,部分病例可见胞浆内空泡,或表现为浆细胞样或横纹肌样形态伴有丰富的嗜酸性胞浆和偏位的核以及胞浆内透明包涵体;可伴有软骨或骨性化生。
5,副脊索瘤现在认为是软组织肌上皮瘤的一种形态学变异型,瘤细胞呈索状排列具有丰富的胞浆内空泡,类似于脊索瘤所见,仅有轻度的核非典型性和稀少的核分裂象;
6,肌上皮肿瘤显示明显的核异型性和活跃的核分裂称之为肌上皮癌,但目前尚无明确的标准用于区分良性和恶性的肌上皮肿瘤。诊断软组织肌上皮癌最令人信服的组织学证据为在良性混合瘤或梭形细胞肌上皮瘤的组织学背景中出现显著的核异型性以及活跃的核分裂象或坏死等,肌上皮癌组织学上可从完全的上皮性癌表现到纯的梭形细胞肉瘤以及小圆细胞肉瘤样不等。

免疫组织化学染色:
诊断软组织肌上皮肿瘤的最低免疫组化染色标准为共表达上皮性标志物(CK 或 EMA)以及 S100 或 SOX10,斑驳状表达 GFAP,部分可表达 SMA 和 calponin,仅少数局灶表达 P63 和 CK5/6;部分病例可显示 INI1 表达缺失,多见肌上皮癌中;混合性可伴有 PLAG1 重排,弥漫核表达 PLAG1 可识别此类肿瘤。
分子标记:
约 44%可见 EWSR1 重排,伴侣基因包括 POU5F1, PBX1, ZNF44 等,软组织混合瘤可显示 PLAG1 基因重排,PLAG1 的 IHC 可助于识别此类肿瘤,部分肌上皮瘤可显示 INI1 缺失。
鉴别诊断:
肌上皮瘤/混合性鉴别诊断:
上皮样外周神经鞘膜瘤:不表达 CK 和 EMA, 以及其他肌上皮标志物;
骨外黏液样软骨肉瘤:不表达上皮性标志物;遗传学显示 N4RA3 基因重排;
脊索瘤:通常发生于中轴骨内,极罕见位于外周软组织;
肌上皮癌:
双相型滑膜肉瘤:表达 TLE1, SS18 重排;
化生性癌肉瘤:如在肺和女性生殖道等需鉴别。
预后:
切除不完整可复发,肌上皮癌具有较高的复发和转移潜能。
治疗:
局部完整切除
参考文献:
Fletcher C D, Bridge J A, Hogondoorn P C, et al. WHO classification of tumours of soft tissue and bone [M]. Lyon: IRAC, 2013. Goldblum J R, Folpe A L, Weiss S W. Enzinger and Weiss's soft tissue tumors [M]. Philadelphia: Saunders, 2014. Flucke U, Palmedo G, Blankenhorn N, et al. EWSR1 gene rearrangement occurs in a subset of cutaneous myoepithelial tumors: a study of 18 cases. Mod Pathol 2011;24:1444–50. Rekhi B, Sable M, Jambhekar NA. Histopathological, immunohistochemical and molecular spectrum of myoepithelial tumours of soft tissues. Virchows Arch 2012;461:687–97. Gleason BC, Fletcher CD. Myoepithelial carcinoma of soft tissue in children: an aggressive neoplasm analyzed in a series of 29 cases. Am J Surg Pathol 2007;31:1813–24.
